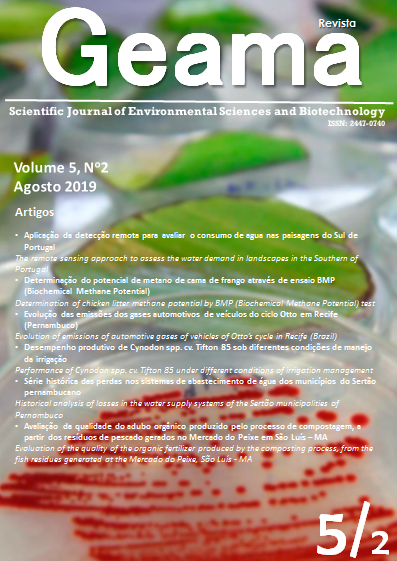

The remote sensing approach to assess the water demand in landscapes in the Southern of Portugal
Palavras-chave:
vegetation indexes, turfgrass, hydrozones, evapotranspiration, landscapeResumo
Landscape irrigation management is an important factor for water conservation, especially in Mediterranean climate with dry and warm summers where the annual average temperature is 170 C and annual precipitation rarely exceeds 700 mm per year. A proper landscape irrigation management to optimize the water use efficiency is achieved by applying the correct amount of water to maintain visual quality of the plants without excessive losses due to deep percolation or runoff.In the absence of landscape water consumption records, vegetation indexes help to determine landscape water demand. Remote sensing provides a tool to assess the evolution of green quality in the landscape.This study aims to evaluate water demand in the Algarve urban landscape in 2016. High-resolution aerial images and climatic records were used to: i) identify and measure the irrigated landscape area; ii) differentiate hydrozones, which are areas covered by plants with similar water needs that were identified by color or patterning; and iii) compare the measured landscape water demand in those areas with vegetation indexes. Combining all information, a better understanding of trends in water demand for Algarve urban landscape was achieved. This is relevant due to the potential for climate change and projections for increasing drought.Downloads
Referências
ALLEN, R.G.; PEREIRA, L.S.; RAES, D.; SMITH, M. Crop Evapotranspiration. Guidelines for Computing Crop Water Requirements, FAO Irrigation and Drainage Paper 56; v. 300, p. D01509, FAO: Rome, Italy, 1998.
ALLEN, R.G.; PEREIRA, L.S.; SMITH, M.; RAES, D.; WRIGHT, J.L. FAO-56 dual crop coefficient method for estimating evaporation from soil and application extensions. Journal of Irrigation and Drainage Engineering, v. 131(1), p. 2–13, 2005.
ANDERSON, Z.; FERMANIAN, T. Early detection of turf disease through direct sensing. GCM, p. 107–110, 2008.
BREMER, D.J.; LEE, H.; SU, K.; KEELEY S.J. Relationships between Normalized Difference Vegetation Index and Visual Quality in Cool-Season Turfgrass: II. Factors Affecting NDVI and its Component Reflectances. Crop Science, v. 51(5), p. 2219–2227, 2011 doi:10.2135/cropsci2010.12.0729.
CARDOSO J.C. A classificação dos solos de Portugal (nova versão). Boletim de Solos, v. 17, p. 14-46, SROA: Lisboa, Portugal. 1974
CRESS J.J.; HUTT M.E.; SLOAN, J.L.; BAUER, M. A.; FELLER M.R.; GOPLEN S.E. US Geological Survey Unmanned Aircraft Systems (UAS) Roadmap. US Department of the Interior, US Geological Survey, 2015. http://dx.doi.org/10.3133/ofr20151032.
GIMENO M.M.; MANZANO, J.; PERALTA, I.B.; GARCIA-SERRA, J. Assessment of urban landscapes management. WIT Transactions on Ecology and the Environment, v. 192, p. 55–65, 2015. doi:10.2495/ECO150061.
GLENN, E.P.; MEXICANO, L.; GARCIA-HERNANDEZ J.; NAGLER, P.L.; GOMES-SAPIENS, M.M.; TANG, D.; LOMELI, M.A.; RAMIREZ-HERNANDEZ, J.;ZAMORA-ARROYO, F. Evapotranspiration and water balance of an anthropogenic coastal desert wetland: Responses to fire, inflows and salinities. Ecological engineering, v. 59, p. 176–184, 2013. https://doi.org/10.1016/j.ecoleng.2012.06.043.
DRAPALG - Direção Regional de Agricultura e Pescas do Algarve. Agrometeorologia (informação atual e séries anuais registados nas EMA), 2017. Available online: http://www.drapalg.min-agricultura.pt/. Accessed 22 September 2018.
JOHNSON, T.D.; BELITZ, K. A remote sensing approach for estimating the location and rate of urban irrigation in semi-arid climates. Journal of hydrology, v. 414, p. 86–98, 2012. https://doi.org/10.1016/j.jhydrol.2011.10.016.
QUI, J.; SU, H.B.; WATANABE, T.; BRUNET, Y. Surface renewal analysis: a new method to obtain scalar fluxes. Agricultural and Forest Meteorology, v. 74(1-2), p. 119–137, 1995 https://doi.org/10.1016/0168-1923(94)02182-J.
ROUSE, J.W. Monitoring the vernal advancement and retrogradation of natural vegetation. NASA/GSFCT Type III, Final Report, v. 371, 1973.
SHAPLAND, T.M.; McELRONE, A.J.; KHAW, T.P.U.; SNYDER, R.L. A turnkey data logger program for field-scale energy flux density measurements using eddy covariance and surface renewal. Italian Journal of Agrometeorology, v. 18(1), p. 5–16. 2013.
SNYDER, R.L.; PEDRAS, C.M.G.; MONTAZAR, A.; HENRY, J.M.; ACKLEY, D. Advances in ET-based landscape irrigation. Agricultural Water Management, v. 147, p. 187–197. 2015. https://doi.org/10.1016/j.agwat.2014.07.024.
SNYDER, R.L.; SPANO D.; DUCE, P.; PAW U, K.T.; RIVERA, M. Surface renewal estimation of pasture evapotranspiration. Journal of irrigation and drainage engineering, v. 134(6), p. 716–721. 2008. doi: 10.1061/(ASCE)0733-9437(2008)134:6(716).
Downloads
Publicado
Como Citar
Edição
Seção
Licença
As Políticas Culturais em Revista aplica a Licença Creative Commons Atribuição-Não Comercial 4.0 Internacional (CC BY-NC-SA 4.0) para os trabalhos que publica. Esta licença foi desenvolvida para facilitar o acesso aberto - ou seja, o acesso livre, imediato, e a reutilização irrestrita de trabalhos originais de todos os tipos. Nossos autores mantêm os direitos autorais mas, sob essa licença, concordam em deixar os artigos legalmente disponíveis para reutilização, sem necessidade de permissão ou taxas, para praticamente qualquer finalidade. Qualquer pessoa pode copiar, distribuir ou reutilizar esses artigos, desde que o autor e a fonte original (Políticas Culturais em Revista) sejam devidamente citados.
![]()